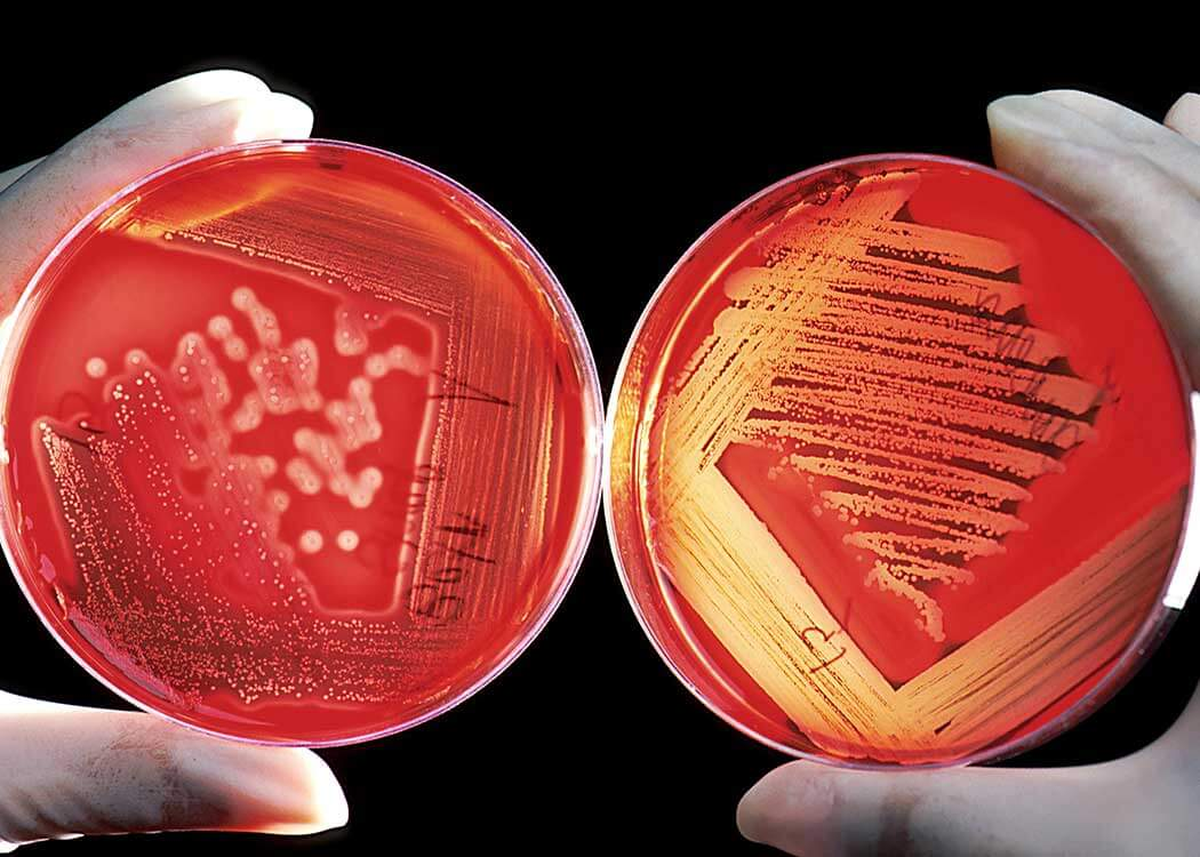
Los cambios serían potenciales. Los cambios serían potenciales.

La búsqueda del sustituto de sangre ideal viene de larga data. Desde las peligrosas transfusiones de leche en el siglo XIX hasta los modernos "transportadores de oxígeno basados en hemoglobina" (HBOCs), la ciencia no paró. Un nuevo proyecto llamado ErythroMer captó la atención del ejército de USA, que decidió invertir nada menos que 46 millones de dólares para su desarrollo.
CHAU, GLÓBULOS ROJOS
Ciencia: USA gastó US$46 millones para encontrar el sustituto de la sangre
La sangre es un tema serio, ya sea en una situación de alto riesgo o para una transfusión. Esta idea de USA tiene mucho potencial. Ciencia 100%.
Quizás también te interese leer: Estudios afirmaron que seguimos evolucionando, pero no como creías
Para la ciencia: ¿Qué tiene de especial este sustituto?
ErythroMer, creado por el científico Allan Doctor y su equipo, es un HBOC de última generación que busca imitar la función de los glóbulos rojos naturales. Imaginate que ErythroMer es como una versión artificial de los glóbulos rojos de nuestra sangre. Es como si fuera un "glóbulo rojo 2.0", creado en un laboratorio.
Lo que lo hace especial es que usa partes de glóbulos rojos viejos (eso es la hemoglobina “reciclada”) y las envuelve en una especie de bolsita artificial súper chiquita. Es como si agarraras el relleno útil de un almohadón viejo y lo pusieras en una funda nueva.
Lo más copado de todo esto es cómo se guarda. ErythroMer se puede convertir en un polvo, parecido al café instantáneo. Podés guardarlo así por años sin que se eche a perder. Cuando lo necesitás, simplemente lo mezclás con agua y ¡listo! Tenés tu sustituto de sangre.
Un ejemplo práctico sería así: Imaginate que estás en medio de la nada y alguien tiene un accidente y necesita sangre urgente. En vez de tener que buscar un donante compatible o un banco de sangre (que probablemente no exista cerca), podrías sacar un sobrecito de ErythroMer, mezclarlo con agua y usarlo para salvar la vida de esa persona.
Los desafíos por superar son muchos para la ciencia
Si bien ErythroMer pinta prometedor, todavía queda camino por recorrer. Los intentos previos de HBOCs tuvieron problemas de toxicidad y efectos secundarios que no fueron menores. El principal desafío es lograr imitar la compleja interacción entre la hemoglobina y el óxido nítrico en los vasos sanguíneos sin causar complicaciones.
Para evitar los problemas de vasoconstricción que tuvieron sus antecesores, ErythroMer apuesta por encapsular la hemoglobina. Este enfoque novedoso está mostrando resultados alentadores en las pruebas con animales, aunque aún falta para llegar a los ensayos clínicos en humanos.
La inversión millonaria de DARPA (la agencia de investigación del Pentágono) demuestra el potencial que ven en este proyecto. Si ErythroMer logra superar todas las pruebas, podría revolucionar la medicina de emergencia y salvar incontables vidas en situaciones críticas.
La ciencia está cada vez más cerca de crear el sustituto de sangre perfecto. Y vos, ¿qué pensás de este avance? ¿Creés que veremos pronto a ErythroMer en acción o todavía falta para que sea una realidad?
----------------------------------------------
Más contenido en Urgente24
Ciencia: Los virus gigantes hallados en el Ártico arrojaron una insólita noticia
La NASA se prepara para lo peor: El Hubble se volvió viejo y se acerca a su fin
La NASA anticipa un espectáculo espacial: Una "bomba de hidrógeno" estelar iluminará los cielos
Historia y conspiraciones de las momias Chinchorro: Las más antiguas del mundo